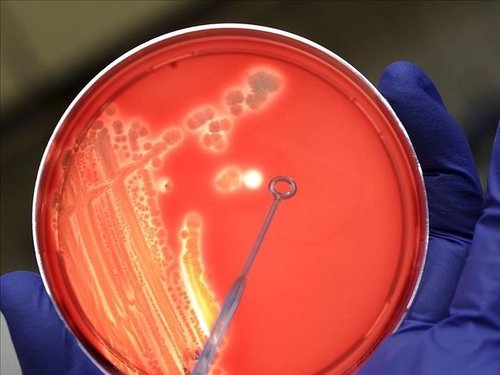

CATEGORÍA: Salud
Nuevo tratamiento para el VIH: un comprimido con dos fármacos
23 enero 2020
Muchas de las personas que viven con VIH en España -los pacientes que inician tratamiento y los que tienen carga viral indetectable- cuentan desde ya con una nueva opción terapéutica tras el lanzamiento de la combinación de dos fármacos en un único comprimido.
Residentes en Farmacia becados por la SEFH exponen diferencias en el rol del FH dentro y fuera de España
22 enero 2020
A través de esta estancia formativa han podido conocer el funcionamiento del servicio de Farmacia Hospitalaria en estos centros y las diferencias y particularidades desde el punto de vista estructural y organizativo, de gestión y en lo relativo a la formación y la investigación.
¿Cómo afectó la exigencia de receta a la venta de ibuprofeno y paracetamol?
21 enero 2020
A lo largo de 2019 se ha incidido en la necesidad de exigir recetas médicas ante la petición por parte del paciente de medicamentos que habitualmente se han podido obtener sin la misma.
La OMS marca 13 prioridades sanitarias urgentes para esta década
20 enero 2020
La Organización Mundial de la Salud incluye alcanzar salarios dignos para los sanitarios entre los retos urgentes junto a la lucha contra la desinformación en la red, el acceso a los medicamentos, la reflexión sobre las implicaciones éticas de nuevas tecnologías como la edición genética.
Un estudio demuestra que un antiviral ayuda a recuperarse antes de la gripe
18 enero 2020
Según los resultados, el oseltamivir permite a los pacientes afectados de gripe recuperarse un día antes en el caso de la población en general y dos o tres días antes a las personas mayores.

Farmacias abiertas y de urgencia más cercanas
Farmacias abiertas y de urgencia más cercanas